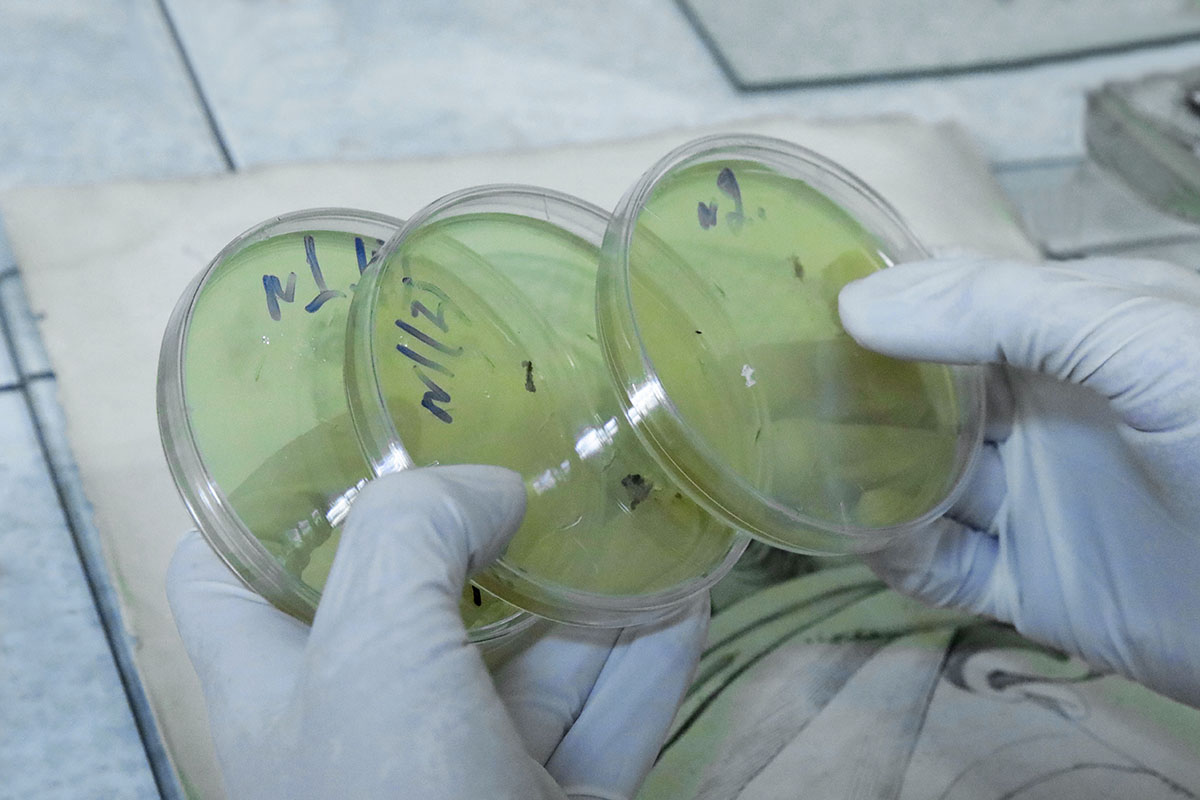

Мастера — участники семинара реставраторов. Часть 2
Мастера. Часть 1
Мастера. Часть 3
Мастера. Часть 4
4—8 апреля в Российской государственной библиотеке пройдёт Шестой Международный научно-практический семинар «Реставрация документа: консерватизм и инновации — 2022» . Как и в предыдущие годы, его участников ждут авторские мастер-классы от лучших специалистов реставрационных центров. На них традиционно демонстрируются как современные, так и редкие старинные технологии.
Продолжаем знакомство с ведущими мастер-классов и практических занятий семинара . Реставраторы и ведущие специалисты Российской государственной библиотеки подготовили серию интересных и разноплановых занятий по совершенствованию профессионального мастерства участников апрельского форума.
5 апреля художник-реставратор отдела реставрации библиотечных фондов РГБ Олеся Андреевна Карабанова приглашает посетить мастер-класс «Идентификация техник печати европейской гравюры» . К этой важной и нужной теме на семинаре обращаются впервые.

Художник-реставратор отдела реставрации библиотечных фондов РГБ
Олеся Карабанова
. Фото предоставлено отделом реставрации библиотечных фондов РГБ
Гравюра — искусство древнее и почтенное, требующее от реставраторов и хранителей как особых знаний, так и деликатного обращения. Олеся Андреевна расскажет о классификации гравюр, выделив три основные техники печати и их подвиды, и даст каждой соответствующую характеристику.
Особое внимание на мастер-классе будет уделено техникам глубокой печати, поскольку в реставрации они встречаются довольно часто.

Фото предоставлено отделом реставрации библиотечных фондов РГБ
Участники мастер-класса узнают, чем офорт отличается от резцовой гравюры и как самостоятельно определить меццо-тинто. Занятия окажутся интересными не только для реставраторов, но и для всех, кому близка тема искусства в целом и гравюры в частности.
Каждый обучающийся получит гравюру и в конце занятия покажет на практике умение верно определить, в какой технике она выполнена.

Фото предоставлено отделом реставрации библиотечных фондов РГБ
Реставраторы и хранители часто сталкиваются с проблемой утраты замков на старых книгах. Они отмечают, что хотели бы научиться восстанавливать металлические застежки на книгах.
6 апреля впервые в истории семинара состоится мастер-класс «Материалы и техника реконструкции книжных замков» , посвящённый этому сложному и интересному творческому процессу. Вас ждёт встреча с художником-реставратором отдела реставрации библиотечных фондов РГБ Игорем Григорьевичем Мосиным. Его занятия начнутся с демонстрации обучающего фильма.

Художник-реставратор отдела реставрации библиотечных фондов РГБ
Игорь Мосин
. Фото предоставлено отделом реставрации библиотечных фондов РГБ
Игорь Григорьевич подготовил образцы латунных заготовок — на них новички будут постигать секреты технологии. Одна из главных задач мастер-класса — научиться правильно обращаться с инструментом. «От того, какой частью руки работает реставратор, очень много зависит: важно научиться работать кистью, а не плечом», — отмечает мастер.
Художник-реставратор отдела реставрации библиотечных фондов РГБ Елена Александровна Калистратова и начальник сектора научно-технической информации АО «НИИП имени В. В. Тихомирова» Татьяна Васильевна Кравченко проведут 6 апреля практическое занятие «Ранняя фотография: её бытование, реставрация, хранение» . Занятие открыто для всех желающих.
«Ранняя фотография, как и любой памятник, нуждается в заботе и защите. Предварительно проводятся изыскательные работы, нужно понять, с какими повреждениями мы имеем дело: механическими, химическими или биологическими. Следует выяснить, чем „болеет“ бумага. От этого зависит дальнейшая работа с ней», — рассказывает Татьяна Васильевна Кравченко.

Художник-реставратор отдела реставрации библиотечных фондов РГБ
Елена Калистратова
. Фото: Мария Говтвань, РГБ
Мастер-класс «Реставрация коллодионных фотографий» Елены Александровны Калистратовой посвящён освоению методики реставрации коллодионных фотографий, работе с различными повреждениями. 7 апреля ведущая расскажет о характерных особенностях этой техники, появившейся на рубеже конца XIX — начала XX века. Участникам мастер-класса будет предложено попробовать самостоятельно восстановить фотографию.

Специалист сектора превентивной консервации отдела реставрации РГБ
Оксана Шадрина
. Фото предоставлено отделом реставрации библиотечных фондов РГБ
Специалист сектора превентивной консервации отдела реставрации РГБ Оксана Владимировна Шадрина на двух мастер-классах научит способам диагностики микробиологических повреждений документа .
Ведущая покажет, как определить наличие или отсутствие микроскопических грибов на документах. Для этого в её распоряжении будут лампа Вуда и чашка Петри. Участники занятий научатся с ними обращаться и узнают, как проводить микробиологическое обследование документов до реставрации и делать посевы с миксомицетов с целью определения их жизнеспособности.

Заведующий сектором превентивной консервации отдела реставрации библиотечных фондов РГБ
Алексей Кащеев
. Фото: Мария Говтвань, РГБ
7 апреля пройдет мастер-класс «Химия в реставрации документа: основные предреставрационные исследования» . Заведующий сектором превентивной консервации отдела реставрации библиотечных фондов РГБ Алексей Анатольевич Кащеев разберёт с участниками мастер-класса методы исследований до и в процессе реставрации: определение кислотности бумаги, определение древесной массы, определение волокон.